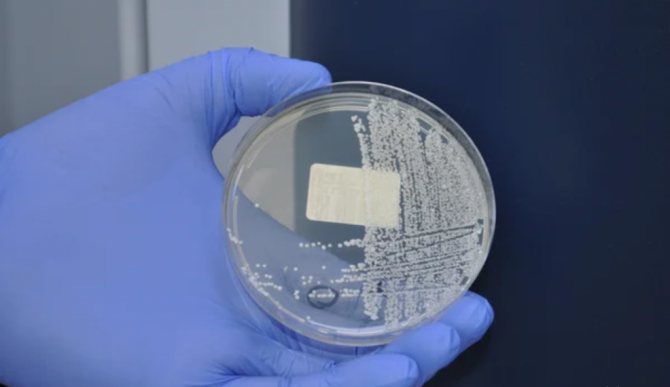

Вирусная экзантема у детей представляет собой одну из наиболее обычных причин кожных высыпаний у младенцев и детей более старшего возраста. Ее основные признаки – появление красной или розовой сыпи на теле ребенка.
Лечение в основном направлено на снижение выраженности симптомов основного заболевания. Экзантема может проявиться как в самом начале болезни, так и испугать родителей уже после, казалось бы, полного выздоровления.
Что такое вирусная экзантема у детей?
Экзантема – это острая реакция организма ребенка на различные инфекции, эта реакция сопровождается появлением на коже краснухоподобной сыпи. Врачи в равной степени регистрируют данное заболевание как у девочек, так и у мальчиков.
Пик заболеваемости приходится на возраст 2-10 месяцев.
Ответная реакция организм с появлением сыпи обусловлена иммунным ответом на инфекционный возбудитель. Иммунитет малышей реагирует на инфекции очень бурно.
Шестая: розеола
Эта болезнь очень пугает родителей, а врачи не всегда ее узнают, что приводит к ненужному назначению антибиотиков. У ребенка внезапно поднимается высокая температура, которая плохо поддается снижению с помощью жаропонижающих средств. Никаких других симптомов нет — ни кашля, ни насморка, ни каких-либо болей.
На самом деле в розеоле нет ничего опасного. Она развивается, когда ребенок заражается вирусом герпеса 6 типа. Происходит это настолько часто, что до 5 лет розеолой успевают переболеть практически все дети. Перенести ее можно только один раз в жизни.
Типичный симптом: ровно через 3 суток температура резко нормализуется (отсюда другое название розеолы – детская трехдневная лихорадка) и еще через сутки появляется сыпь.
Профилактика и лечение
: не требуются — розеола не опасна и проходит самостоятельно.
Как узнать скарлатину и почему «звездочки» на коже — это тревожно
Конечно, этими шестью болезнями список инфекций, которые могут сопровождаться высыпаниями, не исчерпывается. Он довольно большой – это и ветрянка, и энтеровирусная инфекция, и иерсиниоз, и опоясывающий лишай, и многие другие. К сожалению, среди таких инфекций есть и очень опасные, при которых промедление может привести к тяжелым последствиям и гибели человека. Как не пропустить подобные ситуации, на что обращать особое внимание, когда сыпь – тревожный симптом, в каких случаях нужны лабораторные исследования рассказывает врач-педиатр Елена Никифорова, медицинский эксперт лаборатории персонифицированной медицины ЛабКвест.
Виды экзантемы
Существуют следующие разновидности вирусной экзантемы:
- Внезапная — не так давно врачи называли эту экзантему «шестидневной болезнью», так как внезапная экзантема полностью проходит у ребенка за 6 дней. Сейчас этот термин уже не используется, и педиатры ставят диагноз – детская розеола, 3-х дневная лихорадка, псевдокраснуха.
- Вирусная – напоминает кореподобную лекарственную сыпь.
- Бостонская экзантема — эта патология появляется у ребенка при ЕСНО инфекции, ее вызывают 4,9,5,12,18,16 штаммы ЕСНО вирусов, а иногда вирус Коксаки. Возбудители попадают в организм малыша алиментарным или воздушно-капельным путем, в некоторых случаях заражение происходит внутриутробно. По мнению ученых бостонская экзантема активно развивается при лимфогенном распространении вирусных агентов.
- Лекарственная экзантема – провоцируется приемом антибиотиков, проявляется в виде папул и волдырей на коже.
По степени тяжести вирусная экзантема делится на:
- Легкая – высыпаний на теле немного, температура нормальная или повышается до 37,5 градусов.
- Средняя – высыпания покрывают большую часть тела, температура около 38 градусов, сбивается жаропонижающими средствами.
- Тяжелая – в этом случае ребенка госпитализируют, высыпания распространится не только по поверхности кожи, но могут наблюдаться в ротовой полости и на слизистых гениталий. Состояние ребенка тяжелое, температура повышается до критических отметок.
Какой врач лечит экзантему?
При появлении кожной сыпи, сопровождающейся температурой и головной болью, необходимо обратиться к дерматологу или инфекционисту.
Если в местной поликлинике таких специалистов нет, рекомендуется посетить терапевта или записаться на прием к врачу общей практики. Маленького ребенка следует показать педиатру или детскому инфекционисту.
Если у младенца наблюдается сильная лихорадка, диарея, выраженное беспокойство, плач — необходимо вызвать скорую помощь или пригласить на дом врача из детской поликлиники.
Зачастую больные самостоятельно пытаются назначать себе лечение. Для того чтобы избежать дальнейшего распространения воспалительных процессов, люди начинают лечиться антибиотиками. Необходимо понимать, что препараты на антибактериальной основе совершенно не способны уничтожать вирусы. Они воздействуют исключительно на бактерии.
Как лечить вирусную экзантему, интересно многим больным.
К тому же нежелательно использовать во время терапии энтеровирусной экзантемы кортикостероиды. Такие медикаменты негативно сказываются на общем состоянии всего иммунитета, а кроме того, на работе сердечно-сосудистой системы. В норме стероидная терапия должна быть отложена до момента, пока в организме против энтеровируса пациента не начнут вырабатываться необходимые антитела. Именно в связи с этим при появлении кожной сыпи необходимо обратиться за медпомощью и сдать анализы крови. Иначе можно себе навредить.
Симптомы
Клиническая картина вирусной экзантемы заключается в появлении сыпи и повышении температуры, которая держится 4-5 суток. Сыпь под воздействием разных факторов может становиться интенсивнее. Такими факторами могут быть горячая вода, яркий солнечный свет, эмоциональное перенапряжение и прочее. Очень важно оградить малыша от подобных факторов, чтобы не усугубить течение патологии.
У новорожденных детей при экзантеме может усиливаться пульсация родничка.
Общие признаки экзантемы у детей:
- насморк и кашель;
- увеличение лимфатических узлов в области шеи;
- признаки интоксикации организма;
- головная боль;
- слабость;
- расстройство пищеварения;
- ухудшение или отсутствие аппетита.
В зависимости от типа инфекции, симптомы сыпи будут несколько различаться:
- Энетеровирус – сыпь покрывает большую часть тела ребенка, представляет собой мелкие папулы. Имеется интоксикационный процесс.
- Аденовирус – по всему телу наблюдаются розовые пятна, в некоторых случаях развивается кератоконъюнктивит.
- Краснуха и ротавирус – пятна розовые, могут сливаться друг с другом, при близком рассмотрении можно заметить, что они возвышаются над поверхностью кожи.
- Вирус Эпштейна-Барр – высыпания напоминают корь, возможен фарингит и отек век.
- Синдром Джанотти-Крости – ассиметричное расположение сыпи, иногда можно заметить ее слияние.
- Паравирус В-19 – сыпь локализуется на переносице и щеках, иногда отмечается скрытое течение патологии.
Рекомендуем: Анализы на аллергены у ребенка
Симптоматика
Энтеровирусная инфекция у взрослых характеризуется особенным разнообразием клинических проявлений, потому что вирус, как уже упоминалось, способен оседать в различных органах и вызывать разные симптомы даже в пределах одной вспышки заболевания. Соответственно, и внешние проявления, то есть признаки энтеровирусной инфекции могут либо вообще отсутствовать, либо соответствовать разным заболеваниям, которые, бывает, и диагностируются. Понятно, что в таких случаях лечение больной получает неадекватное. Первоначально, размножаясь на слизистых пищевода и верхнего дыхательного тракта, вирус проявляется с симптомами, похожими на ангину, фарингит, ларингит, ОРЗ, ОРВИ, или как расстройство кишечника. Порой могут быть как респираторные, так и кишечные проявления заболевания одновременно.
Ангина, появляющаяся под влиянием энтеровируса, называется герпетической и характеризуется образованием на слизистых оболочках всей полости рта: небе, щеках, миндалинах, языке — язвочек, как при стоматите, отдельно расположенных и между собой поначалу не сливающихся. Герпангина обычно протекает на фоне повышенной температуры, сопровождается болезненными ощущениями в горле при глотании, хотя последний симптом может и отсутствовать. Кишечная форма заболевания может сопровождаться диареей, сильной болью в животе, метеоризмом, рвотой. В респираторной форме больных мучают кашель — как правило, сухой, заложенность носовых ходов и насморк.
Распространяясь по организму, вирус вызывает новые воспалительные реакции. В зависимости от того, какой орган поразила энтеровирусная инфекция, симптомы и лечение может быть абсолютно различными. Чаще всего это может быть лихорадка, длящаяся до трех дней, при небольшой температуре, головокружении и общей слабости, сопровождающаяся сыпью или без нее. Вероятность правильного диагноза при таком состоянии – особенно при отсутствии сыпи — минимальна, и обычно ее лечат как ОРВИ.
Экзантема у детей лечение
Терапевтическая схема лечения вирусной экзантемы выглядит следующим образом:
- Охранительный режим – интоксикация крайне ослабляет организм ребенка, поэтому необходим постельный режим и щадящее питание.
- Восполнение жидкости – в результате температуры, рвоты и диареи организм теряет много жидкости, потому ребенку назначаются Регидрон или Регидрон Био.
- Противовирусная терапия – Ацикловир, Валацикловир или другой, назначенный врачом препарат.
- Жаропонижающие средства – Ибупрофен, Парацетомол или их комбинация.
- Местные анестетики – актуальны при герпетическом стоматите, когда болезненность мешает приему пищи и воды. Назначается Калгель, Лидокаин или препараты на его основе.
- Местные антисептики – препятствуют присоединению вторичной инфекции, ускоряют заживление сыпи. Например, Местамидин.
- Антигистаминные препараты – назначаются при выраженном зуде – Супрастин, Цетризин, Лоратадин. Также можно использовать местную форму препаратов – Псилобальзам, Фенистил.
Длительность лечения зависит от выраженности симптоматики и динамикой ее регресса.
Из средств народной медицины рекомендуется купание ребенка в отварах пихты, чистотела, ромашки. Кожные покровы можно обрабатывать настоями листьев смородины, мяты, калины.
Энантема, что это такое?
Энантема представляет собой локализованное поражение слизистой человека, или другими словами под этим понятием кроется обобщенное название различных высыпаний на слизистых. Зачастую энантемы возникают раньше, чем поражения кожных покровов, за счет чего играют важную роль в диагностике. Это относится к таким заболеваниям, как ящур, корь, герпангина и другие. Энантемы также являются характерным симптомом оспы, краснухи, геморрагической лихорадки.
Экзантема и энантема
Экзантемы и энантемы нередко употребляют вместе. Разница этих понятий заключается в том, что экзантемой называют любую кожную сыпь, имеющую вирусную природу. Энантема же – это высыпания на слизистых. Среди вирусных инфекций, способных вызвать появление сыпи на слизистой и кожных покровов, можно выделить следующие: герпес, корь, энтеровирусы, краснуха, скарлатина, оспа и другие.
Профилактика
Проводить профилактику экзантему у детей не имеет смысла по следующим причинам:
- Никаких 100% эффективных мер не существует. Так как спровоцировать появление экзантемы может огромное количество вирусов, уберечь от всех них ребенка невозможно.
- Сыпь всегда появляется внезапно, и каких-то предпосылок к ее возникновению нет. За исключением сообщений о наличии вирусных эпидемий в том или ином районе.
- Экзантема – это развое заболевание. Однажды перенеся эту инфекцию, человек уже не будет заражаться ею повторно. Педиатры считают, что лучше дать малышу переболеть этим заболеванием в детском возрасте, чем во взрослом – у взрослых людей течение заболевания более сложное.
Также о нецелесообразности профилактики экзантемы говорит тот факт, что 90% детей переносят заболевание легко и без осложнений. У 10% детей патология длится несколько дольше, и может сопровождаться осложнениями. Но и в первом и во втором случае заболевание проходит бесследно.
Несмотря на то, что в большинстве случаев вирусная экзантема протекает в легкой или в средней форме, при возникновении сыпи на теле ребенка родители должны незамедлительно обратиться к врачу. Своевременно назначенная терапия позволит избежать перехода заболевания в тяжелую форму, а также существенно облегчит состояние малыша, и ускорит выздоровление.
Принципы лечения и диагностики
Чтобы поставить диагноз, необходимы клинические данные о заболевании и указания на эпидемиологическую обстановку в регионе. Для точной диагностики энтеровируса и его типа необходимо проведение смывов с носика, горла и попки малыша, все зависит от клинических проявлений и картины болезни.
Обычно полученные смывы засевают на клеточные культуры, и после четырех суток инкубации проводится исследование полученной культуры методом полимеразной цепной реакции с обнаружение вируса. Так как лабораторная диагностика достаточно длительна.
Предварительный диагноз устанавливают на основе клинической картины, а дальнейшая диагностика служит для подтверждения диагноза и не влияет уже на проведение лечения. Специфических препаратов против конкретно энтеровирусов не разработано, лечение обычно проводится дома, госпитализация показана при поражении нервной системы, печени или сердца, при тяжелой лихорадке, не снижающейся привычными средствами.
Ребенок должен находиться в постели на все время лихорадки, питание должно быть по аппетиту и легким, особенно при поражении органов пищеварения и печени. Необходимо пить много жидкости, чтобы не было обезвоживания и токсикоза, это поможет скорейшему снижению температуры и улучшению состояния.
Лечение проводит по симптомам, исходя из уровня поражения – при ангинах это спреи для горла, жаропонижающие препараты и обильное питье, при поносах – методы регидратации, питание и закрепляющие растворы. Все остальные проявления необходимо лечить только под строгим контролем врача и отслеживанием динамики проявлений.
Детей с энтеровирусной инфекцией повергают изоляции на все время их болезни и выходить в детский коллектив им можно только после полного клинического выздоровления.
Основа профилактики энтеровирусной инфекции – строгое соблюдение гигиены и санитарной культуры, мытье рук после туалета и перед едой, питье только кипяченой или специализированной бутилированной воды, запрет на купание в водоемах с сомнительным качеством воды, особенно с проныриванием.
Специфическая вакцина от энтеровирусов не разработана в связи с большим их количеством, хотя в Европе сделаны попытки применения вакцин от самых часто встречающихся энтеровирусов. Использование таких вакцин в будущем поможет снижению заболеваемости различными видами энтеровирусов. Однако пока эффективная вакцина только разрабатывается и применение ее в скором времени не планируется.
Источник: puzkarapuz.ru
Традиционное лечение при энтеровирусной инфекции
Ответ на вопрос чем лечить энтеровирус у детей стоит искать исключительно в кабинете у своего педиатра или семейного врача. Только он может правильно и своевременно распознать симптомы и заподозрить энтеровирусную инфекцию у ребенка. Лечение тоже должен назначать специалист после тщательной диагностики и определения возбудителя.
Медики предлагают два компонента лечения – этиотропное, то есть направленное на причину (возбудителя), и симптоматическое, направленное на устранение и облегчение симптомов.
Из того, что может предложить педиатр или инфекционист для лечения энтеровирусной инфекции стоит отметить следующее. Противовирусная терапия. Интерфероны альфа-2а альфа-2в, которые аналогичны тем, что вырабатывает наш организм, и способны заменить недостающие интерфероны. Это всем знакомые Виферон и Лаферобион в виде капель и свечей.
Ректальная форма имеет смысл только при снятии симптомов диареи. Иммуноглобулины. Назначаются при острых и крайне тяжелых формах энтеровирусной инфекции, таких как менингит или геморрагические состояния. Капсидиннгибитор «Пликонарил», который показал свою эффективность, но до сих пор не прошел регистрацию в ряде стран СНГ.
Симптоматическая терапия. Противорвотные препараты – устранят такие симптомы, как головокружение, тошнота и рвота. К ним можно отнести Церукал, Мотиллиум. Антигистаминные (противоаллергические) средства – устранят аллергические реакции, облегчают катаральные симптомы (насморк, отечность, заложенность).
Это Дезлоратадин (эдэм, эриус) и Фенистил. Жаропонижающие – помогут не только сбить температуру, но и устранят воспалительные признаки – покраснение, боль, сухость. Для детей это Нурофен, Парацетомол или Анальгин + Но-шпа. Средства, способствующие детоксикации кишечника – Атоксил, Смекта, Нифуроксазид, Энтерос-гель, активированный уголь.
Вспомогательная терапия (она же вторая по важности после противовирусной) – частое дробное питье по 5 мл каждые 5 минут, чтобы избежать обезвоживания; прохладный влажный воздух в помещении (18–20 градусов), режим карантина и диета. О ней подробнее ниже. При энеровирусной инфекции у детей питание является одним из компонентов лечения.
Очень важно кормить небольшими порциями, не заставляя ребенка. Питание должно быть обогащено витаминами – сезонными овощами и фруктами. При этом необходимо учитывать специфику протекания вирусной инфекции. Идеально давать фрукты и овощи, приготовленные на пару, тушенные на воде.
Следует убрать из рациона молочные продукты, за исключением нежирного кефира или домашнего йогурта. Не давать ничего жаренного, жирного, острого и соленого. Питание должно быть калорийным, но дробным. Можно давать есть через каждые два-три часа, но небольшими порциями (2–3 столовые ложки при весе 20–25 кг).
Если в картине болезни преобладают нарушения работы ЖКТ, первый день ребенка нужно подержать впроголодь, давая только воду и абсорбенты. Затем в рацион вводятся домашние сухари из белого хлеба, печеные яблоки, обезжиренный кефир или йогурт.
На третий день можно начать давать крупы (рис, гречка на воде), овощные бульоны и супы, свежие апельсины и бананы, галетное печенье, картофельное пюре без яиц и молока. С четвертого дня можно вводить яйца и остальные типичные продукты дробно и часто. Но самое главное правило – часто и дробно поить ребенка до выздоровления.
Источник: pediator4d.ru
Народные средства от сыпи у детей
Если вас мучает сыпь от аллергии и вы не знаете, как вылечить эту проказу, обратитесь к врачу. Но если симптомы несерьезны, прыщи имеют едва красноватый цвет, а заболевание похоже на самую обычную аллергию, убрать сыпь можно и своими силами. Также народные методы отлично подойдут беременным и кормящим мамам, которые всеми силами пытаются сократить прием любых медикаментов. Один из популярных методов – отвар из дубовой коры. Его стоит наносить на все пораженные аллергией места несколько раз в день, и тогда от симптомов не останется и следа. Этот отвар может и заживлять раны, которые возникают из-за расчесывания прыщей. В ближайшей аптеке вы можете купить масляной экстракт шиповника.
Чтобы избавиться таким способом от аллергии, нанесите экстракт на салфетку и промочите им пораженные участки. Применять такое средство можно один или два раза в день. Еще один отличный способ вылечить аллергию – это мазь, собственноручно приготовленная из девясила. Для этого нужно взять его корни, высушить их и измельчить.
Горсть измельченного растения нужно смешать с 4-5 ст. л. несоленого сала. Полученное нужно прокипятить и процедить. Потом лекарство нужно поместить в стеклянную банку и плотно закрыть крышкой. Такая мазь поможет против воспалений, зуда и шелушения. Ингредиент для следующего метода лечения растет у каждого на огороде. Это обычный капустный лист.
Его нужно отбить и прикрепить к пораженному участку кожи. Требуется оставить его так на 2-3 дня. После снять, промыть кожу под ним и вновь наложить лист. Повторить процедуру еще несколько раз. Если вас беспокоит очень сильный зуд, применяйте не примочки, а соки и водные настои. Лучше всего в таких случаях использовать хвощ, боярышник и анютины глазки.
Также в этом случае можно применять ванночки из отваров девятисила, омского каштана или лопуха. Для этого возьмите ч. л. травы, предварительно высушенной и измельченной, и бросьте их в ½ стакана кипятка.
Прокипятите полученный настой в течение 5 минут. Итак, если сыпь стала вашим постоянным спутником, вам следует хорошенько подумать о своих привычках, например о косметике, которой вы пользуетесь или о еде, которую вы употребляете. Вполне возможно, что сыпь – это проявление аллергии, а она может быть вызвана абсолютно всем.
Наши бабушки и дедушки успешно лечили сыпь народными рецептами, самые известные будут представлены ниже. Рецепт уральского целителя Ивана Прохорова. Уральский целитель для снятия сыпи с тела рекомендует чесночное масло. Чесночное масло имеет достаточно долгий срок хранения – около трех месяцев.
Для приготовления народного средства вам необходимо взять несколько головок чеснока, мелко нарезать, положить в глубокую металлическую миску поставить на огонь и медленно добавлять оливковое масло, довести до кипения на медленном огне. После необходимо дать остыть смеси, затем она должна постоять на солнце 10 дней.
Каждый день следует перемешивать смесь около 2-х раз. Через 10 дней необходимо перелить полученную смесь в пластиковую бутылку, предварительно добавив туда эвкалиптовое масло. Наносите средство для лечения сыпи каждый день перед сном. Рецепт против сыпи от Ванги. Она издавна рекомендовала принимать ванну из отвара дубовой коры.
Для приготовления народного средства из дубовой коры необходимо в большой кастрюле с водой отварить ячменные зерна (их можно купить в любой аптеке). если от этого сыпь не исчезнет, то отвар хотя бы предотвратит чесание. Существует и другой рецепт лечения сыпи, основным ингредиентом которого является кора березы.
Для него необходимо отварить дубовую кору, после чего добавить настойку в горячую ванную. В ней необходимо лежать около часа. После принятия ванны необходимо смягчить тело кремом, лучше всего детским, он не вызовет аллергии или покраснений на теле.
Однако следует помнить, что при любых проявлениях кожных заболеваний, необходимо немедленно обращаться к врачу, только он сможет поставить правильный диагноз и определить характер сыпи. Одними бабушкиными рецептами невозможно полностью вылечиться. Фитотерапия поможет вам лишь снять неприятные ощущения и улучшить общее состояние организма.
Одновременно с вышеуказанным настоем можно принимать средство для лечения симптомов аллергической сыпи, для приготовления которого вам понадобится всего 5 граммов порошка яичной скорлупы.
Нужно просто взять скорлупу от 1 яйца, очистить ее от пленки, прокалить в духовке при температуреградусов в течение получаса и растереть пестиком либо с помощью толкушки. Затем просейте скорлупу через сито. Готово! Порошок можно принимать с настоем до исчезновения симптомов аллергической сыпи.
Если вы заметили первые симптомы аллергической сыпи, воспользуйтесь средством для экстренного лечения аллергической сыпи. 1 грамм мумие растворит в 1 литре теплой воды и выпейте такое средство натощак. Использовать данный рецепт можно каждое утро до исчезновения аллергической реакции. Можно употреблять мумие курсами длительностью не менее 3-х недель 2 раза в год для лечения.
Источник: vip-hair.ru
Этиология
Экзантема – это кожные высыпания различной формы, размеров и локализации. Встречается у маленьких детей, реже у подростков. Причины возникновения синдрома будут зависеть от возбудителя.
Основными причинами высыпаний у детей выступают:
- вирус герпеса 6 и 7 типа;
- энтеровирусы Коксаки А, Коксаки В;
- сезонные вирусные заболевания – грипп, респираторные болезни;
- стрептококковые инфекции (бета-гемолитический стрептококк А группы);
- вирусы кори;
- аллергические реакции на медикаменты.
Экзантема и энантема – это не одно и то же, поэтому необходимо различать два этих понятия. Первое затрагивает внешний кожный покров, а вторая патология относится к слизистой оболочке. Инфекционные и вирусные недуги могут сочетать в себе две эти формы и проявляться либо по отдельности, либо вместе.
В отличие от детей, внезапная экзантема у взрослых чаще связана с аллергической реакцией на лекарственные препараты. Детям при назначении лечения постоянно выписываются антигистаминные средства, поэтому аллергическая реакция у них встречается очень редко.
Основной причиной заболеваний этого вида является слабая иммунная система, вирус герпеса. В большинстве случаев патология проявляется после тяжелых респираторных инфекций, когда организм сильно ослаблен.